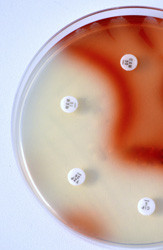

New agrochemicals from bacteria
The BACTOFUNGICIDE project was established to investigate potential biopesticides by studying the genetics of several plant-associated enterobacteria. The aim was to identify the mechanisms behind their bioactivity, which are important for the control of fungal and oomycete (fungal-like) diseases. Particular attention was given to investigating the biosynthesis of the molecule haterumalide oocydin A, which can kill plant pathogenic fungi and oomycetes. It also has the additional benefit of possessing strong anticancer properties. However, although the chemical structure of oocydin A was known, the genes and chemical and anabolic pathways responsible for its biosynthesis were not. Genome sequencing, comparative genomics and chemical analysis were used to identify the large polyketide synthase gene, responsible for the biosynthesis of oocydin A. It was also shown that the oocydin A gene cluster is widely spread and can be found in several plant-associated bacteria belonging to the genera Serratia and Dickeya. A computer model was also proposed for the biosynthesis of oocydin and similar molecules (known as haterumalides), in order to increase their productivity. The model can also be used to generate new chemical analogues of haterumalides with enhanced antifungal, anti-oomycete and anticancer properties. Characterisation of the bacteria stains used by BACTOFUNGICIDE also revealed that some of them display strong anti-nematode properties. Damage due to plant parasitic nematodes is economically significant, with a worldwide annual figure calculated to be over USD 100 billion. The work of BACTOFUNGICIDE was helped by the isolation of a new bacteriophage, phiMAM1. This was used to move chromosomal markers and plasmids between clinical and environmental isolates of Serratia and Kluyvera genera. Genome sequencing, phylogenetic analyses and morphological characterisation of phiMAM1 enabled its classification within the new suggested genus Viunalikevirus. BACTOFUNGICIDE used a multidisciplinary approach to investigate the regulation and biosynthesis of secondary metabolites in several plant-associated bacteria. The results will have long-term implications for agrochemical discovery and crop/food security.